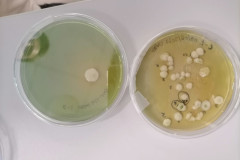

Valorizzazione dei lieviti autoctoni
Da sempre alla ricerca di un prodotto unico che possa rappresentare al meglio e con unicità la nostra azienda nel panorama del Valdobbiadene DOCG, abbiamo iniziato nel 2022 un progetto di ricerca per valorizzare i lieviti indigeni presenti in un nostro vigneto storico.
Durante la vendemmia 2022 abbiamo raccolto da questo vigneto storico circa 150 kg di uva dalle piante più vecchie.
Queste uve sono state micro-vinificate da un laboratorio di ricerca a Conegliano (Coccitech srl). In questa vinificazione spontanea abbiamo selezionato 6 diversi ceppi di lievito Saccharomyces Cerevisiae, appartenente alla famiglia di lieviti utilizzata per la fermentazione alcolica.
 Abbiamo selezionato un lievito con caratteristiche di buona fermentazione per testarlo in cantina, su alcuni mosti della vendemmia 2023.
Abbiamo selezionato un lievito con caratteristiche di buona fermentazione per testarlo in cantina, su alcuni mosti della vendemmia 2023.
Tutti e sei i ceppi, sempre con il mosto della vendemmia 2023, sono stati utilizzati per fare 6 micro-vinificazioni in laboratorio. Finita la fermentazione siamo passati alla fase dei controlli analitici, per verificare l’idoneità di questi lieviti alla fermentazione e, successivamente, siamo passati all’analisi sensoriale dei vini.
 Il pannel di degustazione è stato composto dalla nostra cantina in collaborazione con i responsabili di Coccitech srl. La degustazione ha permesso di selezionare 3 ceppi di lievito con caratteristiche interessanti.
Il pannel di degustazione è stato composto dalla nostra cantina in collaborazione con i responsabili di Coccitech srl. La degustazione ha permesso di selezionare 3 ceppi di lievito con caratteristiche interessanti.
Attualmente in cantina abbiamo una piccola quantità di vino prodotta in vendemmia con uno di questi lieviti e produrremmo una piccola quantità di bottiglie di vino a fermentazione in bottiglia, utilizzando in seconda fermentazione i nostri lieviti.
Stiamo affinando i nostri test per estendere la produzione di questi vini, espressione dei nostri vigneti e della nostra storia.